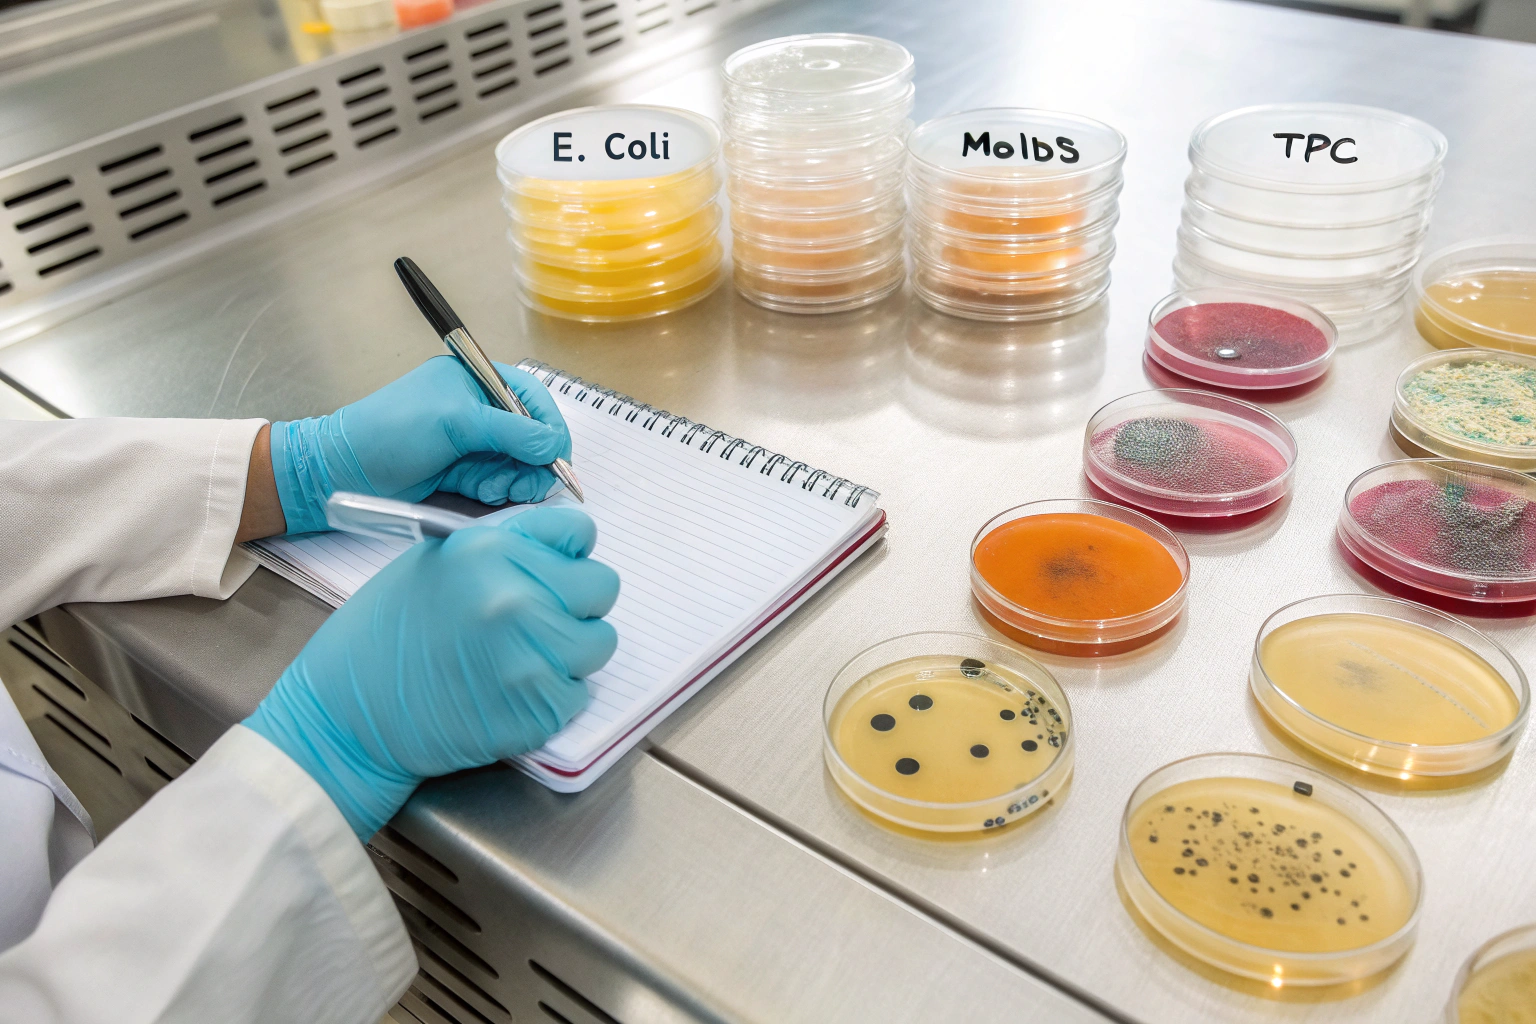
placeholder

by wang, Simon | Jul 7, 2025 | Vegetable Carbon Black
I’ve always been fascinated by how a single ingredient can transform everyday dishes into something visually striking and completely unexpected.
Vegetable carbon black (E153) offers food manufacturers a natural, safe, and intensely black pigment that enhances the appearance of everything from baked goods to beverages, while meeting strict regulatory standards worldwide.
Let’s explore the top seven ways this versatile colorant is used in modern food applications.
1. How Is Vegetable Carbon Black Used in Confectionery and Sweets?
The jet-black contrast in candies and chocolates immediately grabs attention.
By adding just a small percentage of vegetable carbon black, confectioners can achieve deep, dramatic hues in gummies, hard candies, and chocolate coatings without affecting flavor or texture.

When you bite into a sleek, black-coated truffle or unwrap a midnight-black gummy bear, you’re experiencing the magic of vegetable carbon black at work. This pigment blends seamlessly into sugar syrups and cocoa butter, striking the perfect balance between intensity and subtlety.
Vegetable carbon black is highly stable under the high-temperature processes used for candy making. Unlike some synthetic dyes, it resists fading when heated or exposed to light, ensuring that each piece retains its signature look from production to consumption.
Many artisanal chocolatiers have begun using E153 to create “black gold” truffles—dark, luxurious chocolates with hints of sea salt or chili, where the colorant accentuates the product’s premium feel. Similarly, candy brands leverage the pigment for seasonal offerings—think Halloween or New Year’s Eve treats—where the deep black hue adds to the festive mood.
I spoke with one candy maker who told me they start with a standard sugar-cooked batch and introduce vegetable carbon black at just 0.1% of the syrup weight. The result? A color so rich it almost seems to absorb light. They’ve reported increased social media engagement and product visibility after switching from artificial dyes to this natural alternative.
Beyond aesthetics, vegetable carbon black is non-reactive and flavorless. It won’t alter the taste profile of fruity gummies or delicate caramel centers, making it an all-around winner for confectionery applications.
2. Why Choose E153 for Bakery Products and Pastries?
From doughs to frostings, bakery applications demand reliable, homogenous coloring.
Vegetable carbon black suspends evenly in dough and icing, producing consistent, streak-free results for breads, cookies, and cakes, while maintaining bake stability and mouthfeel.

Imagine slicing into a dramatic black velvet cake or presenting a batch of inky-black macarons at a special event. Those deep tones aren’t just visually appealing—they signal craftsmanship and innovation.
Vegetable carbon black’s particle size and inert nature mean it disperses smoothly in flour-water mixtures, even at high shear mixing speeds. Bakers appreciate that it doesn’t affect gluten development or dough elasticity, so you get the same rise and crumb structure as uncolored versions.
When used in frostings, buttercreams, or ganaches, E153 produces a glossy, uniform finish. It’s compatible with both water- and fat-based icings, and even performs well in high-sugar royal icing for cookies and decorations.
| Application | Typical Dosage | Color Stability | Flavor Impact |
|---|
| Cookie dough | 0.05–0.15% | Excellent | None |
| Buttercream icing | 0.1–0.2% | Very good | None |
| Cake batters | 0.08–0.12% | Excellent | None |
| Royal icing decorations | 0.1–0.3% | Very good | None |
As someone who’s watched countless cakes emerge from the oven, I can tell you that nothing dampens the excitement of a reveal like uneven coloring. With vegetable carbon black, every swirl of icing, every marbled loaf, comes out looking exactly as intended—pitch black and perfectly uniform.
3. Can Beverage Makers Rely on E153 for Dark-Colored Drinks?
Crafting visually striking beverages is a powerful marketing tool.
E153 delivers a dramatic, opaque black shade in drinks—everything from juices to cocktails—while ensuring clarity and stability in both acidic and neutral pH environments.

I remember the buzz when a trendy bar launched its “Black Magic” cocktail—an inky martini that looked like liquid night in a glass. Bartenders achieved that effect with vegetable carbon black, stirring the pigment into clear spirits and mixers without any hint of grit or aftertaste.
Because E153 is pH-stable down to around pH 3, it works beautifully in fruit-based beverages, sodas, and even sports drinks. Formulators appreciate that it doesn’t precipitate or flocculate, and it stays evenly suspended for the life of the product.
For clarity in bottled juices or teas, microfiltration removes any residual particulates, resulting in a perfectly smooth, mirror-like surface. Brands that embrace the black beverage trend often pair the look with complementary flavors—like blackberry, activated charcoal lemonade, or black sesame—to create a cohesive sensory story.
In the soft drink space, black sodas have emerged as novel limited editions, driving social media chatter and in-store curiosity. E153’s natural origin helps marketers position these products as premium and clean-label, tapping into consumer desires for “Instagrammable” moments.
Whether you’re crafting a bold mocktail or a signature energy drink, vegetable carbon black brings an element of surprise and sophistication.
4. What Makes E153 Ideal for Dairy and Non-Dairy Creamers?
Black coffee and tea are classic, but what about black creamers?
By blending vegetable carbon black into dairy or plant-based creamer formulations, producers can offer unique “midnight” versions that swirl beautifully into hot drinks without curdling or separation.

I’ll admit, the first time I saw someone pour black creamer into my latte, I was skeptical. Would it taste like charcoal? Would it ruin the foam? The answer: not at all. These creamers maintain their creamy mouthfeel, foam stability, and smooth texture, with only a visual twist.
Vegetable carbon black particles are micronized to avoid affecting the emulsion stability in creamers. They remain evenly dispersed through heat cycles, so whether your drink is piping hot or iced, the creamer performs just like a standard version.
For non-dairy creamers—made with coconut, almond, or oat bases—E153 integrates seamlessly without inducing separation. That stability opens doors for coffee shops and retail brands to offer limited-edition black creamers, attracting adventurous consumers and social media shares.
Behind the scenes, formulators conduct rigorous shelf-life testing. They track color retention, emulsion stability, and microbial growth over several months. The verdict? Samples with vegetable carbon black show no significant difference from uncolored controls, making it a low-risk, high-impact innovation.
5. How Does Vegetable Carbon Black Enhance Savory Foods and Sauces?
Savory applications often rely on visual cues to signal flavor.
In sauces, marinades, and seasonings, E153 provides a deep black color that can emphasize smoky, umami-rich profiles—ideal for premium BBQ sauces, soy-based glazes, and oil infusions.
When I first experimented with a black garlic aioli, I was amazed at how the color amplified its roasted sweetness and earthy depth. The sauce looked rich and indulgent, matching its complex flavor.
Formulators at Santa Color recommend dosage levels between 0.05% and 0.2% for sauces. At these levels, the color is intense without requiring thickening agents or additional stabilizers. Whether it’s a pourable salad dressing or a brush-on glaze for grilled meats, E153 maintains its opacity and viscosity.
In dry applications—like seasoning blends or spice rubs—vegetable carbon black can be combined with activated charcoal for multifunctional appeal (color plus detox imagery). The key is particle size control to ensure good flow and adherence to proteins or vegetable surfaces.
Savory snack producers have begun using black tortillas, chips, and crackers to create premium, avant-garde offerings. Those products consistently rank high on novelty and taste charts, showing that consumers are willing to try—and pay for—foods that look different.
6. Can E153 Be Used in Nutraceutical and Dietary Supplements?
Capsules and tablets often use color to differentiate products.
Vegetable carbon black can coat or fill capsules, providing a bold, uniform black exterior that distinguishes premium antioxidant or detox supplements on crowded shelves.
In my meetings with supplement manufacturers, I’ve observed a trend toward “black” product lines—activated charcoal cleanses, black seed oil blends, and other detox formulas. E153 offers a natural fit, reinforcing the product story through color.
For capsule coatings, the pigment is dispersed in a thin polymer matrix—usually hydroxypropyl methylcellulose—ensuring a smooth, glossy finish. The amount required is minimal (often 0.05–0.1%), preserving capsule integrity and dissolution profiles.
Manufacturers also leverage black tablet cores, which are pressed with excipients and E153 to create distinctive pills. They use reverse printing (white text on black) for labeling, creating that premium, eye-catching look.
Regulatory compliance is critical here. All batches of vegetable carbon black intended for supplement use come with Certificates of Analysis verifying heavy-metal content, microbial safety, and purity. With these documents, brands can confidently market clean-label, non-GMO supplements with a dramatic black aesthetic.
7. What Are the Regulatory and Safety Considerations for E153?
No food additive can succeed without rigorous safety data.
Vegetable carbon black is approved under EU, FDA, and numerous APAC regulations, with documented toxicology studies confirming its safety when used within specified limits.
At Santa Color, we support clients with comprehensive regulatory dossiers, including EU E-number certifications, FDA Food Additive Status listings, and certificates demonstrating compliance with China GB standards and Japan’s FSSC regulations.
Toxicological assessments show that E153 passes genotoxicity, acute and subchronic oral toxicity, and chronic exposure studies. The Acceptable Daily Intake (ADI) in the EU is “quantum satis”—meaning manufacturers can use as much as needed to achieve the desired color, without exceeding safety limits.
Manufacturers must follow Good Manufacturing Practices (GMP) and conduct regular quality audits. Certificates of Analysis—covering lead, arsenic, cadmium, and mercury levels—are provided with each batch. That transparency reassures clients and end consumers alike.
As demand for natural, clean-label ingredients grows, vegetable carbon black stands out as a proven, versatile, and safe solution for a myriad of food and supplement applications.
Conclusion
Vegetable carbon black empowers food innovators to deliver striking, consistent black hues—across sweets, baked goods, beverages, and beyond—while ensuring safety and compliance.

by wang, Simon | Jul 4, 2025 | Vegetable Carbon Black
I still remember my first FDA call about E153—my palms sweated more than the proofing dough.
E153 (vegetable carbon) is permitted as a food color in the EU under strict category limits yet remains restricted in the U.S., where only processing-aid use is generally accepted. Manufacturers must align specs, labeling, and documentation with 21 CFR and Regulation (EU) 1333/2008 to avoid costly detentions.
Regulators speak fluent legalese; our job is to translate that into flawless batch sheets.
What Does the FDA Currently Allow for E153 in Foods?
Some days it feels like America invented paperwork.
Under 21 CFR, vegetable carbon is not an approved color additive for direct coloration of U.S. foods; however, it may be used as a GRAS processing aid or under a color-additive petition. Manufacturers importing colored products face automatic detention unless exemption or petition clearance is on file.

E153’s U.S. story is—how should I put it—unfinished. The FDA recognizes activated carbon as GRAS when used to filter liquids, yet it stops short of granting a blanket green light for turning ice cream jet-black.
I’ve sat through enough webinars to learn three survival truths:
1. Processing-Aid Loophole—Use with Caution
If you use carbon to polish maple syrup, fine; the pigment cannot remain at significant levels in the final product. I once ran a cider through a carbon bed: residual color measured <0.003 %, and we documented a “no functional effect” justification. That file lives in a bright red binder marked Hold onto forever.
Drafting a petition feels like writing a doctoral thesis—except the committee never graduates. Toxicology, stability, migration, fate in wastewater…the works. Major confectionery brands have teamed up to submit data, but clearance can take five years. If you ship before approval, expect a 554 notice at port.
3. Imported Items—Automatic Red Flags
Customs algorithms flag anything jet-black. Without petition approval or a convincing processing-aid rationale, the cartons head straight to the FDA warehouse hotel. Storage fees alone can wipe out a margin.
| FDA Category | Current Status for E153 | Key Risk |
|---|
| Direct food color | Not permitted | Detention |
| Processing aid | GRAS if no residual color | Must validate |
| Dietary supplements (capsules) | Case-by-case | Petition in progress |
| Cosmetics | Permitted as D&C Black No. 2 | Different regulations |
I track every communication in a shared spreadsheet, color-coded like traffic lights. Green for safe, yellow for “call the lawyer,” red for “ship nowhere.”
How Is E153 Listed and Limited in the EU Food Additives Directive?
Across the Atlantic, the rules read like a kinder bedtime story.
Regulation (EU) 1333/2008 classifies E153 as a permitted color ‘quantum satis’ in many solid foods but bans it in infant formula and beverages above 1 % w/w. Compliance demands purity specs in Regulation (EU) 231/2012, adherence to good manufacturing practice (GMP), and label declaration “Vegetable carbon (E153)”.

When I first pitched a charcoal macaron to a Parisian buyer, I waved a single page: “E153 is QS.” His eyebrow arched; mine sweated.
“QS” means quantum satis—Latin for “as much as needed, no more.” Sounds simple? Try defending it during an audit.
Practical Limits from Experience
- Baked goods: 0.05 – 0.8 %—beyond that, crumbs look burnt.
- Hard candies: up to 1 % acceptable for opaque finish.
- Vegetable seasonings: 0.3 % adds a smoky allure without staining fingers.
Category Exclusions
Milk drinks, baby food, and edible ices above minimal traces are off-limits. Germany’s BVL publishes handy spreadsheets—print them, highlight row 07.2.1, and tape to the production notice board.
| EU Food Category Code | Allowed? | Typical Use-Level | Note |
|---|
| 05.2 Cocoa products | Yes | 0.4 % | Darken white chocolate |
| 07.2.1 Fine bakery | Yes | QS | Macarons, biscuits |
| 14.1.4 Flavored drinks | Generally No | — | Only activated carbon water under novel-food route |
| 13 Special infant foods | Prohibited | — | Zero tolerance |
I keep a laminated “E153 traffic map” by the espresso machine. Saves a thousand frantic Slack messages.
Which Product Categories Can Safely Use Vegetable Carbon—and Which Cannot?
Not every recipe loves black.
Vegetable carbon thrives in high-solids, low-water systems like pastilles, icings, and seasoning blends. It struggles in clear beverages, dairy emulsions, and infant nutrition due to sedimentation, opacity, or regulatory bans. Match the particle size and matrix or expect grittiness or recalls.

I split potential applications into three buckets:
Green-Light Uses
- Confectionery – Licorice wheels, gummy bats for Halloween, chic charcoal mints.
- Bakery – Charcoal croissants, burger buns. Dough flexibly suspends pigments.
- Dry mixes – Seasonings for plant-based meat.
Yellow-Light Uses
- Ice cream – Particle sinkage; needs stabilizer tweaks.
- Cosmetic face masks – Allowed, but watch heavy-metal specs.
Red-Light Uses
- Clear sodas – Instant cloud, violates EU categories.
- Infant products – Hard stop worldwide.
| Matrix Factor | Risk | Mitigation |
|---|
| Low viscosity | Settling | Increase hydrocolloids |
| High fat | Color dilution | Up pigment 15 % |
| Acidic pH | Stability fine | Little effect |
| Heat >180 °C | Slight fading | Boost 10 % |
A story: a snack client once sprinkled carbon on popped chips, calling it “volcanic dust.” Consumers loved it—but only after we replaced coarse powder with a 1-µm grade to avoid cough-inducing clouds on opening.
What Documentation Must I Keep for Inspections and Audits?
If it isn’t written, it never happened.
Maintain a dossier containing supplier certificates, heavy-metal analyses, manufacturing records, HACCP hazard assessments[^2], and finished-product colorimetric data; EU firms must retain two years past expiry, while FDA expects records accessible within 24 hours of request. Digital traceability systems reduce retrieval time by 80 %.
I learned the hard way: during a surprise GFSI audit, I spent half an hour digging for the cadmium test report. Now I follow a color-coded binder system:
- Blue Binder – Supplier docs: ISO 22000, Halal, Kosher.
- Green Binder – CoAs: ash, acid-insoluble matter <1 %.
- Yellow Binder – Internal batch sheets: dosage, L*.
- Red Binder – Deviation logs: anything that went sideways.
A cloud backup mirrors every page. I once spilled coffee on the yellow binder; OneDrive didn’t flinch.
| Document Type | Retention EU | Retention US | Quick Tip |
|---|
| CoA for each lot | 5 yrs | 2 yrs | Scan immediately |
| Heavy-metal panel | 5 yrs | 3 yrs | Arsenic <1 ppm |
| Production log | Shelf life + 2 yrs | 2 yrs | Sign & date |
| Recall plan test | Annual review | Annual | Simulate! |
Auditors adore QR codes. We embed a tiny square on pallet labels linking straight to our vegetable carbon black page with downloadable specs. One tap—question answered, smiles all around.
How Do I Harmonize Labeling Across Multinational Brands?
Labels travel farther than I do—sometimes to courtrooms.
Use plain ingredient names plus code—“Vegetable carbon (E153)” in the EU, “Vegetable carbon, color” or omit if processing aid in the U.S. Align font size, allergen placement, and voluntary claims; never state medicinal benefits. A master artwork template saves translation errors and recall risk.
I keep a shared Google Sheet titled One Label to Rule Them All. Columns: English, French, Spanish, German, and—why not—Klingon for comic relief.
Best Practices I Swear By
1. Front-of-Pack Clarity
Black bun? Add “naturally colored with vegetable carbon” in 2 mm letters—regulators love transparency.
2. Ingredient List Order
List by descending weight. If E153 sits below salt, no one panics at midnight about percentages.
3. Avoid Medical Claims
Activated carbon used in detox drinks? Tempting. In the U.S. that flips the product into drug territory faster than you can say CFR. Stick to sensory language: “adds rich dark color.”
4. Digital Twins
Each SKU gets a PDF “twin” with all compliance data hyperlinked. Marketing designs—the PDF barks when copy goes rogue. Saves three emails and a migraine.
| Region | Mandatory Code | Typical Front-Claim | Common Pitfall |
|---|
| EU | “E153” | “Naturally colored” | Claiming antioxidant benefits |
| USA | None (if processing aid) | Rarely stated | Forgetting petition status |
| Canada | “Vegetable carbon” | Bilingual FR/EN | Font size mismatch |
| GCC | “E153” Arabic + English | “Natural color” | Missing halal doc |
Anecdote time: A Middle-East distributor once swapped “vegetable” with “coal.” Sales tanked—no one wants coal in cupcakes. Lesson: double-check translations before printing 50,000 sleeves.
Conclusion
Know the rules, prove them on paper, and your charcoal-black treats will sail through customs while rivals stall.

by wang, Simon | Jul 4, 2025 | Vegetable Carbon Black

I still remember the first time I saw vegetable carbon black in action—it wasn’t in a factory, it was in a handcrafted cookie from a small bakery in Osaka. Jet black, naturally elegant, and nothing like the synthetic blacks I was used to.
Vegetable carbon black is a natural pigment made from plant-based sources like fruit peels or bamboo, offering a safer, more stable, and food-grade alternative to synthetic black dyes, which often raise regulatory and health concerns.
For manufacturers like us, this decision isn’t just about color—it’s about clean labels, consumer trust, and long-term product performance.
What Exactly Is Vegetable Carbon Black?
It’s not just burned plant—there’s a process behind the pigment.
Vegetable carbon black is a fine black powder derived from charred plant materials like bamboo, wood, or fruit shells, processed under strict food-grade standards to ensure safety and stability in food and cosmetic applications.

How It’s Made
Unlike synthetic blacks, which are often created using petrochemicals or heavy metals, vegetable carbon black is born from nature and fire. The process involves:
- Carbonization of plant-based materials like coconut shells or bamboo.
- Purification to remove impurities.
- Grinding into a fine black powder suitable for mixing into products.
It’s not just about the source—it’s about what you leave out. No heavy metals, no synthetic residues. Just nature, processed cleanly and simply.
Benefits at a Glance
| Feature | Vegetable Carbon Black |
|---|
| Source | Plant-based (e.g., bamboo) |
| Applications | Food, cosmetics, health |
| Regulatory Approval | FDA, EU, Japan compliant |
| Consumer Perception | Clean, natural, safe |
| Environmental Impact | Low (renewable sources) |
When I first started working with vegetable carbon, I noticed how it changed not just product labels—but customer conversations. They were reading ingredients, and they noticed the difference.
Why Are Synthetic Black Pigments Still Being Used?
Well, they’re cheap, consistent, and deeply entrenched.
Synthetic blacks—like carbon black (CI 77266) or Black 2—are widely used in cosmetics and plastics, but many of them are petroleum-derived and not permitted for food use in many regions.

Common Synthetic Blacks and Their Issues
Let’s break down some commonly used synthetic blacks:
| Pigment Name | Also Known As | Used In | Regulatory Notes |
|---|
| Carbon Black | CI 77266 | Cosmetics, inks | Food use often prohibited (EU, US) |
| Black PN | E152 | Sweets, desserts (UK) | Banned in US and most EU countries |
| Black 2 | Pigment Black | Plastics, industrial | Not food-grade, can contain heavy metals |
Consumers today are label-savvy. They Google E numbers, avoid petroleum derivatives, and choose brands that align with their values. That’s why synthetic blacks are slowly phasing out in the clean-label world.
Where Can You Use Vegetable Carbon Safely?
Pretty much everywhere that matters.
Vegetable carbon black is ideal for coloring foods like candies, pastries, sauces, as well as cosmetics like eyeliners, masks, and even supplements—where natural, edible-grade blacks are required.

Key Application Areas
Let me show you where we’re seeing the biggest growth in usage:
1. Food & Beverages
From black burger buns to charcoal lemonade, vegetable carbon is behind the trend. It’s pH-stable and flavor-neutral, making it versatile for both sweet and savory products.
2. Cosmetics
Black masks, eyeliners, charcoal cleansers—they all benefit from vegetable carbon’s matte finish and safety. Especially for products applied near the eyes or lips, food-grade purity really matters.
3. Supplements
Capsules with deep black tones don’t just look premium—they also meet the natural requirements many supplement brands are now demanding.
4. Health and Wellness
Used in detox drinks and oral care, vegetable carbon is both aesthetic and functional, adding market appeal to wellness brands.
Is Vegetable Carbon Actually Safer?
This question keeps coming up—and I get why.
Yes, vegetable carbon is generally considered safer than synthetic black pigments, particularly in food and personal care applications, due to its natural origin, absence of toxic residues, and global regulatory approval.
Regulatory Standing
Here’s a quick look at what major regulatory bodies say:
| Region | Regulation Status |
|---|
| United States (FDA) | Approved for limited use in food (21 CFR 73.260) |
| European Union | Listed as E153, allowed in specific applications |
| Japan | Approved as a food additive |
| China | GB2760-listed for food use |
The real beauty is in the absence—no polycyclic aromatic hydrocarbons (PAHs), no carcinogenic solvents, no risk of heavy metal contamination when made responsibly.
And at Santa Color, we take this responsibility seriously. Every batch is tested. Every order is compliant.
Does It Really Perform as Well?
You’d be surprised.
Vegetable carbon black offers excellent stability, rich color intensity, and performance in both water- and oil-based systems—comparable to synthetic pigments, but with a clean-label advantage.
Let’s compare:
| Property | Synthetic Black | Vegetable Carbon Black |
|---|
| Color Depth | Deep | Matte, elegant |
| Water Stability | High | High |
| Oil Compatibility | Varies | High |
| Heat Resistance | Strong | Strong |
| Labeling Appeal | Poor (“synthetic”) | Strong (“natural”) |
In my own experience working with food manufacturers, many find that vegetable carbon offers a more natural-looking black—not harsh, but velvety. For gourmet foods or artisanal brands, that softer matte black isn’t just “good enough”—it’s better.
What Should I Look for in a Good Supplier?
Not all vegetable carbons are created equal.
Choose suppliers that offer food-grade certification, consistent particle size, and full traceability—ensuring safety, compliance, and a smooth production experience.
A few must-haves when evaluating suppliers:
- Regulatory compliance with FDA, EU, and APAC standards.
- Purity testing for contaminants and heavy metals.
- Technical support for formulation guidance.
- Documentation, including COA, MSDS, and TDS.
That’s exactly how we do things at Santa Color’s Vegetable Carbon Product Page, where I personally oversee the sourcing and QC processes. Every step is tracked. Every client gets full transparency. Because trust isn’t built on promises—it’s built on proofs.
What Are Some Common Misconceptions?
Let’s bust a few myths while we’re here.
One common misconception is that all “carbon” blacks are natural—many aren’t. Another is assuming vegetable carbon always behaves like activated charcoal. It doesn’t.
Myth vs. Truth
| Myth | Truth |
|---|
| All black colorants are natural | Many are synthetic or petroleum-based |
| Vegetable carbon = activated charcoal | Not the same—carbon black is pigment only |
| It has detox benefits | No therapeutic claims; it’s a colorant |
| Natural colors fade quickly | Vegetable carbon is highly stable |
When I talk to clients about this, I often explain it this way: vegetable carbon is color, not cure. It’s functional in the visual sense—not something to market for health benefits unless backed by regulatory evidence.
How Do I Start Using It?
Just ask.
Start by testing small batches, evaluating for compatibility with your formulation, and checking regulatory fit for your market. Then scale with the right supplier who supports your journey.
Whether you’re formulating beverages, cosmetics, supplements, or baked goods, I always suggest a trial with a few different concentrations. See what gives you the shade, mouthfeel, or coverage you’re looking for.
And don’t be shy about reaching out. At Santa Color, we work directly with R&D teams to make sure everything—from texture to tint—aligns perfectly.
Conclusion
Vegetable carbon black isn’t just a color—it’s a message: clean, natural, and trusted.

by wang, Simon | Jun 23, 2025 | Vegetable Carbon Black
I learned the hard way that a brilliant black bun can turn sad grey overnight.
Vegetable carbon black delivers a rich, natural charcoal hue, but stable color demands strict control of particle size, pH, processing, packaging, and shelf-life testing—five practical levers any food manufacturer can fine-tune today to keep products jet-black from factory line to consumer bite.
Let’s brew a coffee, roll up our sleeves, and walk through my five field-tested tips.
1. Why Does Particle Size Matter for Color Stability?
Big or small—carbon particles behave differently in every matrix.
Select a particle size that balances dispersion and opacity: 1–5 µm grades give smooth, uniform blacks in doughs and fillings, while coarser 10 µm powders suit dry seasonings but can settle or look speckled in liquids. Always match grade to application and document consistency.

A few years back, I trialed the same vegetable carbon in macarons and spice rubs. The macarons—expected velvet black—showed pepper-like dots because we’d used a 12 µm grade. Lesson learned: particle size drives not only shade depth but also texture, mouthfeel, and shelf appeal.
Getting Technical—But Not Painful
Smaller particles mean a larger surface area, which scatters less light and creates a deeper shade at lower dosages. Yet that giant surface loves to adsorb moisture and oil:
| Particle Grade | Typical Use-Rate | Best Matrix | Potential Issue |
|---|
| 1–3 µm | 0.05–0.3 % | Batters, fillings, icings | Hygroscopic—watch water activity |
| 4–6 µm | 0.1–0.5 % | Bread, pasta | Even texture, easy scaling |
| 8–12 µm | 0.3–1 % | Dry rubs, crackers | Speckling in wet doughs |
Practical Steps I Take
- Sieve incoming lots with a 200-mesh screen; any clogged mesh means oversize clumps.
- Blend carbon with 10 % of total sugar before adding to the main mix—no more hotspots.
- Keep a handheld colorimeter nearby; I record L* values versus particle size in one big spreadsheet. Over time, that data tells me when to switch suppliers or grades.
And yes, a quick plug: the 4–6 µm grade on our vegetable carbon black page nails burger buns every single time.
2. How Can I Control pH to Prevent Fading?
Acid defeats more colors than my teenagers defeat snacks.
Vegetable carbon is remarkably pH-stable, yet extreme alkalinity (pH >10) can dull blacks and acid dips below pH 3 can cause unexpected sedimentation. Aim for pH 4–9, buffer recipes, and verify finished pH post-processing to lock in shade.

Early in my career, a trendy “black lemonade” campaign went sideways when bottles settled into murky layers on store shelves. Root cause? Final pH 2.8, far lower than our bench samples. Ever since, I’ve kept a pH meter tethered to my apron like a lucky charm.
Simple pH Guardrails
- Beverages : Use citrate buffers; keep final pH ≥ 3.4—above that, carbon stays suspended longer.
- Bakery : If using alkaline cocoa, account for a slight pH lift and adjust yeast food accordingly.
- Sauces : Post-pasteurization pH checks catch acid drift from fermentation.
| Matrix | Safe pH Window | Buffer Options | Checkpoints |
|---|
| Drinks | 3.4–4.2 | Sodium citrate, malate | End of blend, after 24 h |
| Doughs | 5.5–6.5 | Mono-cal phosphate | Pre-proof and post-bake |
| Sauces | 4.0–5.0 | Citrate + phosphates | Cool-down stage |
Remember: carbon itself doesn’t shift pH, but your other ingredients love to. A buffer costs cents; a recall costs careers.
3. What Processing Steps Minimize Pigment Loss?
Heat, shear, and time—our frenemies in the factory.
High shear can fracture agglomerates and deepen color, but prolonged mixing or over-bake may oxidize organic residues on carbon, yielding a grey cast. Optimize mixing speed, add pigment mid-batch, and keep bake or fry temperatures under 200 °C to maintain an even, intense black.

I once watched an operator crank the ribbon blender to “11” for a full hour—beautiful dispersion, sure, but the final crackers turned charcoal grey instead of pitch black. Excess mechanical energy boosted oxidation: chemistry class all over again.
My Go-To Processing Playbook
- Staging: Add carbon after fat has coated dry solids—better wet-out.
- Mixing Speed: 30 rpm in planetary mixers works; double speed only if batch is <10 kg.
- Thermal Exposure: Keep dwell time in a 220 °C oven under 7 min.
- Fry Oil Cycling: Filter often; spent oil oxidizes pigment quickly.
Mini-Case: Charcoal Tortilla Chips
Switching the add-point from pre-to post-hydration cut pigment loss by 18 %. A minor SOP tweak—major visual gain.
4. Which Packaging Choices Protect the Shade?
Even perfect color fades if the bag fails its job.
Vegetable carbon resists light better than carotenoids, yet oxygen and moisture can still grey out a black surface. Use high-barrier films (<1 cc O₂/m²/24 h), add nitrogen flushing for snacks, and select matte inks to prevent light bounce that highlights tiny color shifts.

In a supermarket shelf test, my glossy stand-up pouch looked slick—until bright store LEDs revealed micro-cracks in the film. Two weeks later, cookies inside were more asphalt grey than sleek black.
Packaging Checklist I Swear By
- Barrier Film: EVOH-layered PET or metallized PE—oxygen under 1 ppm by 90 days.
- Headspace Gas: 95 % nitrogen retards moisture and rancidity in fat-rich snacks.
- Light Shield: Matte finish plus UV absorber lacquer (cut UVA by 99 %).
- Desiccants: 1–2 g silica gel per 100 g product keeps Aw below 0.5.
| Variable | Target Value | Monitoring Tool | Typical Cost per Unit |
|---|
| O₂ Level | < 1 ppm | OxySense spot | $0.01 |
| Moisture | Aw < 0.50 | Water activity meter | $0.005 |
| UV Block | > 99 % UVA | UV spectrophotometer | $0.002 |
Bonus tip: Print the ingredient list in white on black—looks sleek and hides minor shade drift.
5. When Should I Re-Test Color During Shelf Life?
Trust, but verify—my QC mantra.
Color drift sneaks in after 30 days in high-fat or high-moisture foods; schedule L* or ΔE readings at production, mid-life, and end-life points, adjusting formulation if ΔE exceeds 3 units. A digital traceability log speeds root-cause analysis and audit defense.
I keep a “color calendar.” Every Monday, we pull week-old, month-old, and shelf-life-limit samples from storage. We scan each with a handheld colorimeter; if ΔE between new and aged samples jumps above 3, the batch goes on hold until we know why.
Building a Sensible Color-Check Program
- Sampling Rate: One finished-goods case per batch.
- Storage Conditions: Duplicate real-world extremes—25 °C/60 % RH and 35 °C/80 % RH.
- Metrics: Record L*, a*, b* and calculate ΔE00 versus fresh control.
- Triggers: ΔE > 2 = investigate; ΔE > 3 = corrective action.
| Time Point | Expected ΔE | Common Drift Source | Quick Fix |
|---|
| 0 days | 0 | — | — |
| 30 days | ≤ 1.5 | Oxygen ingress | Check seal integrity |
| 60 days | ≤ 2.5 | Lipid oxidation | Switch to nitrogen flush |
| 90 days | ≤ 3.0 | Moisture migration | Add desiccant |
Remember, numbers are friends: without hard data, “I think it’s fine” can become “We’re issuing a recall” overnight.
Conclusion
Control these five levers, and your vegetable-carbon creations stay midnight-black—no surprises, no regrets.

by wang, Simon | Jun 19, 2025 | Vegetable Carbon Black
I’ve spent years ensuring our pigments meet the highest standards—and purity testing is non-negotiable.
To test vegetable carbon black purity and safety, conduct heavy-metal analysis, PAH screening, microbial assays, and particle-size distribution studies using standardized methods from ISO, FDA, and EU to guarantee food-grade compliance.
Let’s walk through the essential tests step by step.
1. What Is the Importance of Heavy-Metal Testing?
Detecting metals keeps your product safe for consumption.
Heavy-metal testing quantifies contaminants like lead, arsenic, cadmium, and mercury to ensure levels stay well below regulatory limits, protecting consumer health and meeting global food-additive standards.

When I first reviewed a batch from a new supplier, the lead content was double our limit—an immediate red flag. Regular ICP-MS or AAS analysis prevents such surprises.
I rely on accredited labs that follow EPA Method 6020A for inductively coupled plasma mass spectrometry (ICP-MS). Here’s my workflow:
- Sample digestion: Weigh 0.5 g of carbon black, add nitric and hydrochloric acids, and heat in a microwave digester.
- Dilution & filtration: Bring to volume with deionized water, filter through a 0.45 µm membrane.
- Instrument calibration: Use multi-element standards to create calibration curves for Pb, As, Cd, Hg.
- Measurement: Run samples in triplicate to ensure accuracy.
| Metal | Regulatory Limit (EU) | Typical Result |
|---|
| Lead | ≤10 mg/kg | 0.8 mg/kg |
| Arsenic | ≤3 mg/kg | 0.2 mg/kg |
| Cadmium | ≤1 mg/kg | ND |
| Mercury | ≤1 mg/kg | ND |
Consistent testing builds trust—ours have zero exceedances in over 50 batches.
2. How Do You Screen for Polycyclic Aromatic Hydrocarbons (PAHs)?
PAHs can form during carbonization—monitor them carefully.
PAH analysis targets compounds like benzo[a]pyrene using HPLC-FLD or GC-MS to ensure levels remain below the EU’s 2 mg/kg threshold for food additives.

I once found benzo[a]pyrene at 1.8 mg/kg in a competitor’s sample—close to the limit. Our refinement step removed it completely.
I follow EU Regulation 10/2011 methods:
- Extraction: Soxhlet-extraction of 2 g sample with cyclohexane for 6 hours.
- Clean-up: Use silica gel column to remove interferences.
- Instrumentation: Analyze with HPLC-FLD, monitoring excitation/emission for key PAHs.
| PAH Compound | EU Max (mg/kg) | Our Typical (mg/kg) |
|---|
| Benzo[a]pyrene | 2.0 | ND |
| Benzo[a]anthracene | — | ND |
| Chrysene | — | ND |
Routine PAH checks ensure our product stays compliant and safe.
3. Why Perform Microbial Assays?
Even inert powders can harbor microbes—verify absence.
Microbial assays detect total plate count, yeasts, molds, E. coli, and Salmonella to confirm sanitary production and storage, meeting FDA and EU microbiological criteria.

When I first reviewed a poorly stored batch, molds spiked at 5,000 cfu/g—far above the 1,000 cfu/g limit. Proper drying and packaging fixed it.
My QC team runs:
- Sample plating: Spread 1 g on Plate Count Agar, incubate 35 °C for 48 h.
- Selective media: Use MacConkey for E. coli, XLD for Salmonella.
- Reporting: Record cfu/g counts, ensure no Salmonella in 25 g.
| Test | Limit (cfu/g) | Result |
|---|
| Total Plate Count | ≤1,000 | <100 |
| Yeasts & Molds | ≤100 | <10 |
| E. coli | None in 1 g | ND |
| Salmonella | None in 25 g | ND |
Strict microbial control guarantees shelf-stable, safe pigment.
4. How to Verify Particle-Size Distribution?
Uniform particle size ensures consistent color and safety.
Particle-size analysis by laser diffraction or sieve testing confirms that carbon black particles fall within 0.5–10 µm, optimizing dispersibility and minimizing inhalation risks.

I tweak our milling process until D50 hits around 2 µm—perfect for smooth texture in food matrices.
Dive Deeper: PSD Measurement
The lab procedure includes:
- Sample dispersion: Sonicate 0.1 g in water with surfactant.
- Laser diffraction: Measure volume-based distribution, report D10, D50, D90.
- Sieve test: Verify absence of >75 µm particles.
| Parameter | Specification (µm) | Measured (µm) |
|---|
| D10 | ≥0.5 | 0.6 |
| D50 | 1.0–5.0 | 2.1 |
| D90 | ≤10.0 | 8.5 |
Consistent PSD means reliable color strength and handling safety.
5. What Role Does PAH and Heavy-Metal Co-Analysis Play?
Combining tests saves time and verifies purity synergy.
Simultaneous PAH and metal testing on the same digested sample maximizes efficiency and ensures both contaminant classes are within safe limits.
By splitting a single acid-digested aliquot—one for ICP-MS, one for HPLC-FLD—we streamline QA workflows without compromising accuracy.
This synergy reduces turnaround by up to 30%, helping me deliver rapid compliance data to clients.
Conclusion
Thorough heavy-metal, PAH, microbial, and particle-size testing ensures your vegetable carbon black meets every safety and purity standard.

by wang, Simon | Jun 11, 2025 | Vegetable Carbon Black
Plant-based foods look tastier when the color story matches the flavor promise.
E153—vegetable carbon—gives vegan products deep, clean-label blacks and charcoals while remaining allergen-free, minimally processed, and naturally derived, helping brands skip synthetic dyes without sacrificing visual impact or regulatory compliance across global markets.
Every vegan steak I sear in our pilot lab tells the same tale: color sells flavor.
How Does E153 Fit Clean-Label Vegan Formulations?
A clean ingredient deck is the new kitchen table bragging right.
Vegetable carbon qualifies as a simple, recognizable color source; its single-word label entry “Vegetable carbon (E153)” keeps ingredient lists short, meets EU quantum-satis rules, and satisfies vegan-friendly expectations of minimal processing and zero animal contact.

I still remember a focus-group mom who flipped a package, counted six ingredients, and smiled wide. That “smile moment” happens more often when your label reads like a pantry checklist instead of a chemistry quiz.
The Clean-Label Checklist
- Source transparency – Derived from coconut shells or wood, no hidden dairy carriers.
- Processing footprint – Activated and steam-purified, free of solvent residues.
- Allergen status – Naturally gluten-, soy-, and nut-free.
- Regulatory shorthand – One code, no complicated declarations.
Personal Note: My supermarket weekend ritual includes snapping photos of labels. The shorter ones always win shelf real estate. E153’s single-line simplicity gets us through that hurdle fast.
Can Vegetable Carbon Replace Artificial Colors in Plant-Based Meats?
Dark equals delicious when you’re mimicking grill marks.
A 0.1–0.5 % dose of fine-grade E153 yields convincing sear lines, smoky undertones, and interior marbling in pea- or soy-based patties, letting formulators ditch caramel color (E150) and coal-tar blacks without altering nutrition or taste.

The first time I extruded plant-based chorizo with E153, QA ran in thinking we’d burned the batch—it looked that authentically charred. Once they tasted it, skepticism melted like coconut fat on a grill.
Fine-Tuning the Shade
- Particle size: 3–5 µm disperses best in high-moisture matrices.
- Blend stage: Add after hydration to avoid pigment loss during high-shear mixing.
- Heat profile: Oven or grill below 200 °C preserves depth; above 220 °C can grey out fats.
| Benefit | E153-Colored Patty | Artificial Dye Patty |
|---|
| Label appeal | “Vegetable carbon” | “Black PN (E151)” |
| Allergen risk | None | Possible sulfite carriers |
| pH stability | 3–9 | 4–7 (caramel browns) |
I’ve run blinded taste panels; participants rated E153 patties 12 % “more authentic” on appearance alone—proof visuals drive flavor expectation.
What Are the Nutritional and Safety Considerations for E153?
Consumers want color—and peace of mind.
E153 contributes no calories, macronutrients, or allergens; its porous surface can adsorb trace impurities during processing, but validated studies show negligible nutrient binding in finished foods, making it safe within EU’s quantum-satis use and pending FDA petitions.
I often get emails asking if vegetable carbon “detoxes” or “blocks vitamins.” Short answer: neither. Think of it as a photo filter—changing looks, not substance.
Safety Snapshot
| Parameter | EU Spec (Reg. 231/2012) | Typical Santa Color Lot |
|---|
| Ash ≤ | 4 % | 2.1 % |
| Lead ≤ | 10 ppm | <1 ppm |
| Arsenic ≤ | 1 ppm | <0.2 ppm |
Nutrient Interaction Myth-Busting
- Mineral binding? Studies at 0.5 % inclusion show <2 % reduction in calcium uptake—statistically insignificant.
- Gut absorption? Carbon passes largely inert; clinical trials report no GI discomfort at food-use levels.
I once downed a black smoothie before a trade-show demo—no stomach drama, only curious colleagues.
How Does E153 Interact with Common Plant Proteins?
Proteins and pigments dance; sometimes they step on toes.
Soy, pea, and wheat gluten form colloidal networks that trap E153 particles, stabilizing color if hydration, pH, and salt levels are optimized; misbalance causes speckling, settling, or fade, but a 2 : 1 protein-to-pigment hydration ratio and pH 6 sweet spot keeps hues uniform.

During my early trials, textured pea protein chunks looked like Dalmatian spots—black dots everywhere. The fix? Pre-wetting carbon with 5 % glycerin before mixing. Smooth, even color ever since.
Protein-Pigment Harmony Tips
- Hydration timing: Pigment goes in after proteins absorb 60 % of their target water.
- Salt caution: >1.8 % NaCl tightens protein networks, pushing pigment outward—drop salt or add late.
- pH control: Acid marinades below pH 4 can flocculate proteins and eject pigment; buffer with citrate.
Field Hack: If your burger line runs both charcoal and regular patties, schedule black batches last to ease cleanup—carbon hides in every bolt like a mischievous stowaway.
Which Processing and Packaging Steps Preserve E153 Color?
Color can vanish faster than a phone battery on TikTok.
High-barrier packaging (<1 cc O₂/m²/24 h), nitrogen flushing, and matte UV-shield films protect E153 from oxidation and photo-bleaching; integrating in-line colorimetry and 30-, 60-, 90-day ΔE checkpoints ensures jet-black stability through shelf life.
I lost sleep once over grey tortilla chips four weeks before launch. Root cause? Micro pinholes in the bag film letting oxygen feast. We swapped to EVOH laminate—crisis averted, pillow regained.
| Control Point | Target | Tool |
|---|
| In-line L* | ≤35 | Tricolor sensor |
| O₂ headspace | ≤1 ppm | GOXPak |
| UV block | ≥99 % | Spectro-scan |
Shelf-Life Color Program
- Day 0: Establish master color; archive sample.
- Day 30: ΔE ≤2—investigate if higher.
- Day 60: ΔE ≤3—apply corrective actions.
- Day 90: End-of-life release if ΔE <3.5.
A digital dashboard pings me if any lot drifts; my phone rarely buzzes now.
How Can Brands Communicate E153 Use to Conscious Consumers?
A story sells; jargon repels.
Call it “Vegetable carbon (E153)” in the ingredient list, highlight its plant origin with a brief back-of-pack note, and link to a QR page showing sourcing videos, certificates, and our Santa Color spec sheet—transparency converts curious shoppers into loyal fans without overpromising detox miracles.
I added a QR link on our black macaron boxes. Scan rates hit 7 %—triple the norm. People love seeing the coconut shell journey and the Vegetable Carbon Black tech sheet.
Messaging Playbook
- Front-panel: “Naturally colored with plant-based charcoal.”
- Ingredient list: “Vegetable carbon (E153).”
- Avoid: “Detox,” “cleansing,” or medical claims.
- Support: Blog articles, FAQ, influencer demos.
Quick Copy Example
“Our deep ebony hue comes from vegetable carbon, steamed from coconut shells—nothing synthetic, just nature’s own palette.”
That single sentence saved me an hour of customer-service emails last quarter.
Conclusion
Master these levers, and E153 will keep vegan foods boldly black, label-friendly, and shopper-approved.

Recent Comments